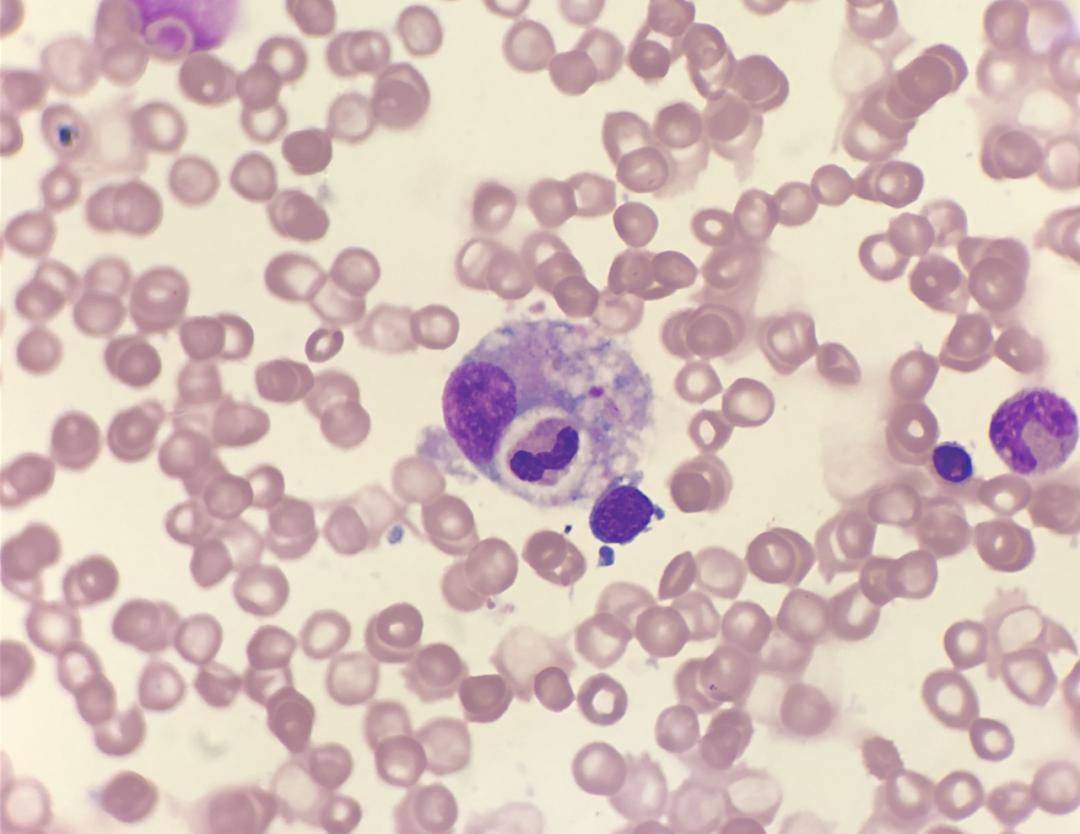
不久,患儿骨髓标本送检至检验科,对其染色镜检,可见吞噬红细胞

ALP染色

碱性磷酸酶(alp)染色
图片尺寸491x488
成纤维细胞生长因子受体在成骨细胞中的表达及作用研究
图片尺寸874x786
alp碱性磷酸酶染色服务,又称alp染色,是用于检测骨细胞,骨组织,肾,肝
图片尺寸1440x1440
(a)第1,3,7,14天的alp染色;展示了具有代表性的图像.
图片尺寸616x703
成骨细胞alp碱性磷酸酶染色钙钴法(gomori法)染色结果图,请求指教
图片尺寸1920x1440
我前几天刚做的,也是这种颜色.这样对吗?
图片尺寸2560x1920
alp staining, intracellular alp activity, collagen secretion
图片尺寸784x834
图5a中不同组骨髓间充质干细胞alp染色图重复(tns-pem与tns-pem-igf1
图片尺寸705x683
【求助】请大家帮忙看看我的成骨细胞alp染色
图片尺寸2272x1704
runx1对牙髓干细胞的增殖及成骨,成脂分化的影响
图片尺寸3150x1796
【求助】碱性磷酸酶,茜素红,von kossa染色
图片尺寸1600x1200
北京博奥森生物技术有限公司
图片尺寸1360x1024
多管齐下一种有望修复骨质疏松性骨缺损的复合水凝胶
图片尺寸684x816
段师形态教学系列第73期
图片尺寸1000x1029
(a)将bm-mscs经alp染色后在诱导培养基中不同的表面培育7天的图像(b)
图片尺寸500x372
脐带间充质干细胞成骨诱导
图片尺寸1242x1656
不久,患儿骨髓标本送检至检验科,对其染色镜检,可见吞噬红细胞
图片尺寸1080x834
a)hbmsc的alp表达.b)hbmsc的ars染色.c)huvec的cd31表达.
图片尺寸1267x650
hey1表达对bmp9诱导下c3h10t12细胞的成骨分化及增殖影响
图片尺寸700x373
bmscs成骨诱导3 d后观察(a~f)及成骨诱导7 d后alp染色观察(g~l)
图片尺寸700x389